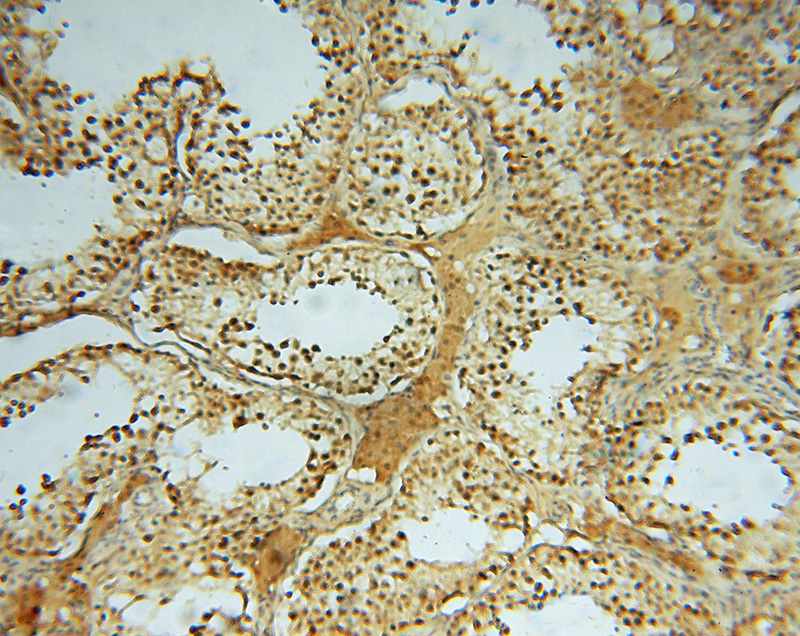
Immunohistochemical of paraffin-embedded human testis using Catalog No:111374(HDAC2-specific antibody) at dilution of 1:50 (under 10x lens)

-
Product Name
HDAC2-specific antibody
- Documents
-
Description
HDAC2-specific Rabbit Polyclonal antibody. Positive WB detected in HepG2 cells, A431 cells, HeLa cells, human liver tissue. Positive IHC detected in human testis tissue, human brain tissue, human heart tissue, human kidney tissue, human liver tissue, human ovary tissue, human skin tissue, human spleen tissue. Positive IF detected in HeLa cells. Observed molecular weight by Western-blot: 55kd
-
Tested applications
ELISA, WB, IHC, IF
-
Species reactivity
Human,Mouse,Rat; other species not tested.
-
Alternative names
HD2 antibody; HDAC2 antibody; histone deacetylase 2 antibody; RPD3 antibody; YAF1 antibody
-
Isotype
Rabbit IgG
-
Preparation
This antibody was obtained by immunization of Peptide (Accession Number: NM_001527). Purification method: Antigen affinity purified.
-
Clonality
Polyclonal
-
Formulation
PBS with 0.02% sodium azide and 50% glycerol pH 7.3.
-
Storage instructions
Store at -20℃. DO NOT ALIQUOT
-
Applications
Recommended Dilution:
WB: 1:500-1:5000
IHC: 1:20-1:200
IF: 1:10-1:100
-
Validations

HepG2 cells were subjected to SDS PAGE followed by western blot with Catalog No:111374(HDAC2-specific antibody) at dilution of 1:500
Immunohistochemical of paraffin-embedded human testis using Catalog No:111374(HDAC2-specific antibody) at dilution of 1:50 (under 10x lens)

Immunohistochemical of paraffin-embedded human testis using Catalog No:111374(HDAC2-specific antibody) at dilution of 1:50 (under 40x lens)

Immunofluorescent analysis of HeLa cells using Catalog No:111374(HDAC2-specific Antibody) at dilution of 1:25 and Rhodamine-Goat anti-Rabbit IgG
-
Background
Histone deacetylases(HDAC) are a class of enzymes that remove the acetyl groups from the lysine residues leading to the formation of a condensed and transcriptionally silenced chromatin.Histone deacetylases act via the formation of large multiprotein complexes, and are responsible for the deacetylation of lysine residues at the N-terminal regions of core histones (H2A, H2B, H3 and H4). At least 4 classes of HDAC were identified. As a class I HDAC, HDAC2 was primarily found in the nucleus. HDAC2 forms transcriptional repressor complexes by associating with many different proteins, including YY1, a mammalian zinc-finger transcription factor. Thus, it plays an important role in transcriptional regulation, cell cycle progression and developmental events. This antibody is a rabbit polyclonal antibody raised against a peptide mapping within human HDAC2 and is specific to HDAC2. It will not cross react with other HDACs.
Related Products / Services
Please note: All products are "FOR RESEARCH USE ONLY AND ARE NOT INTENDED FOR DIAGNOSTIC OR THERAPEUTIC USE"
